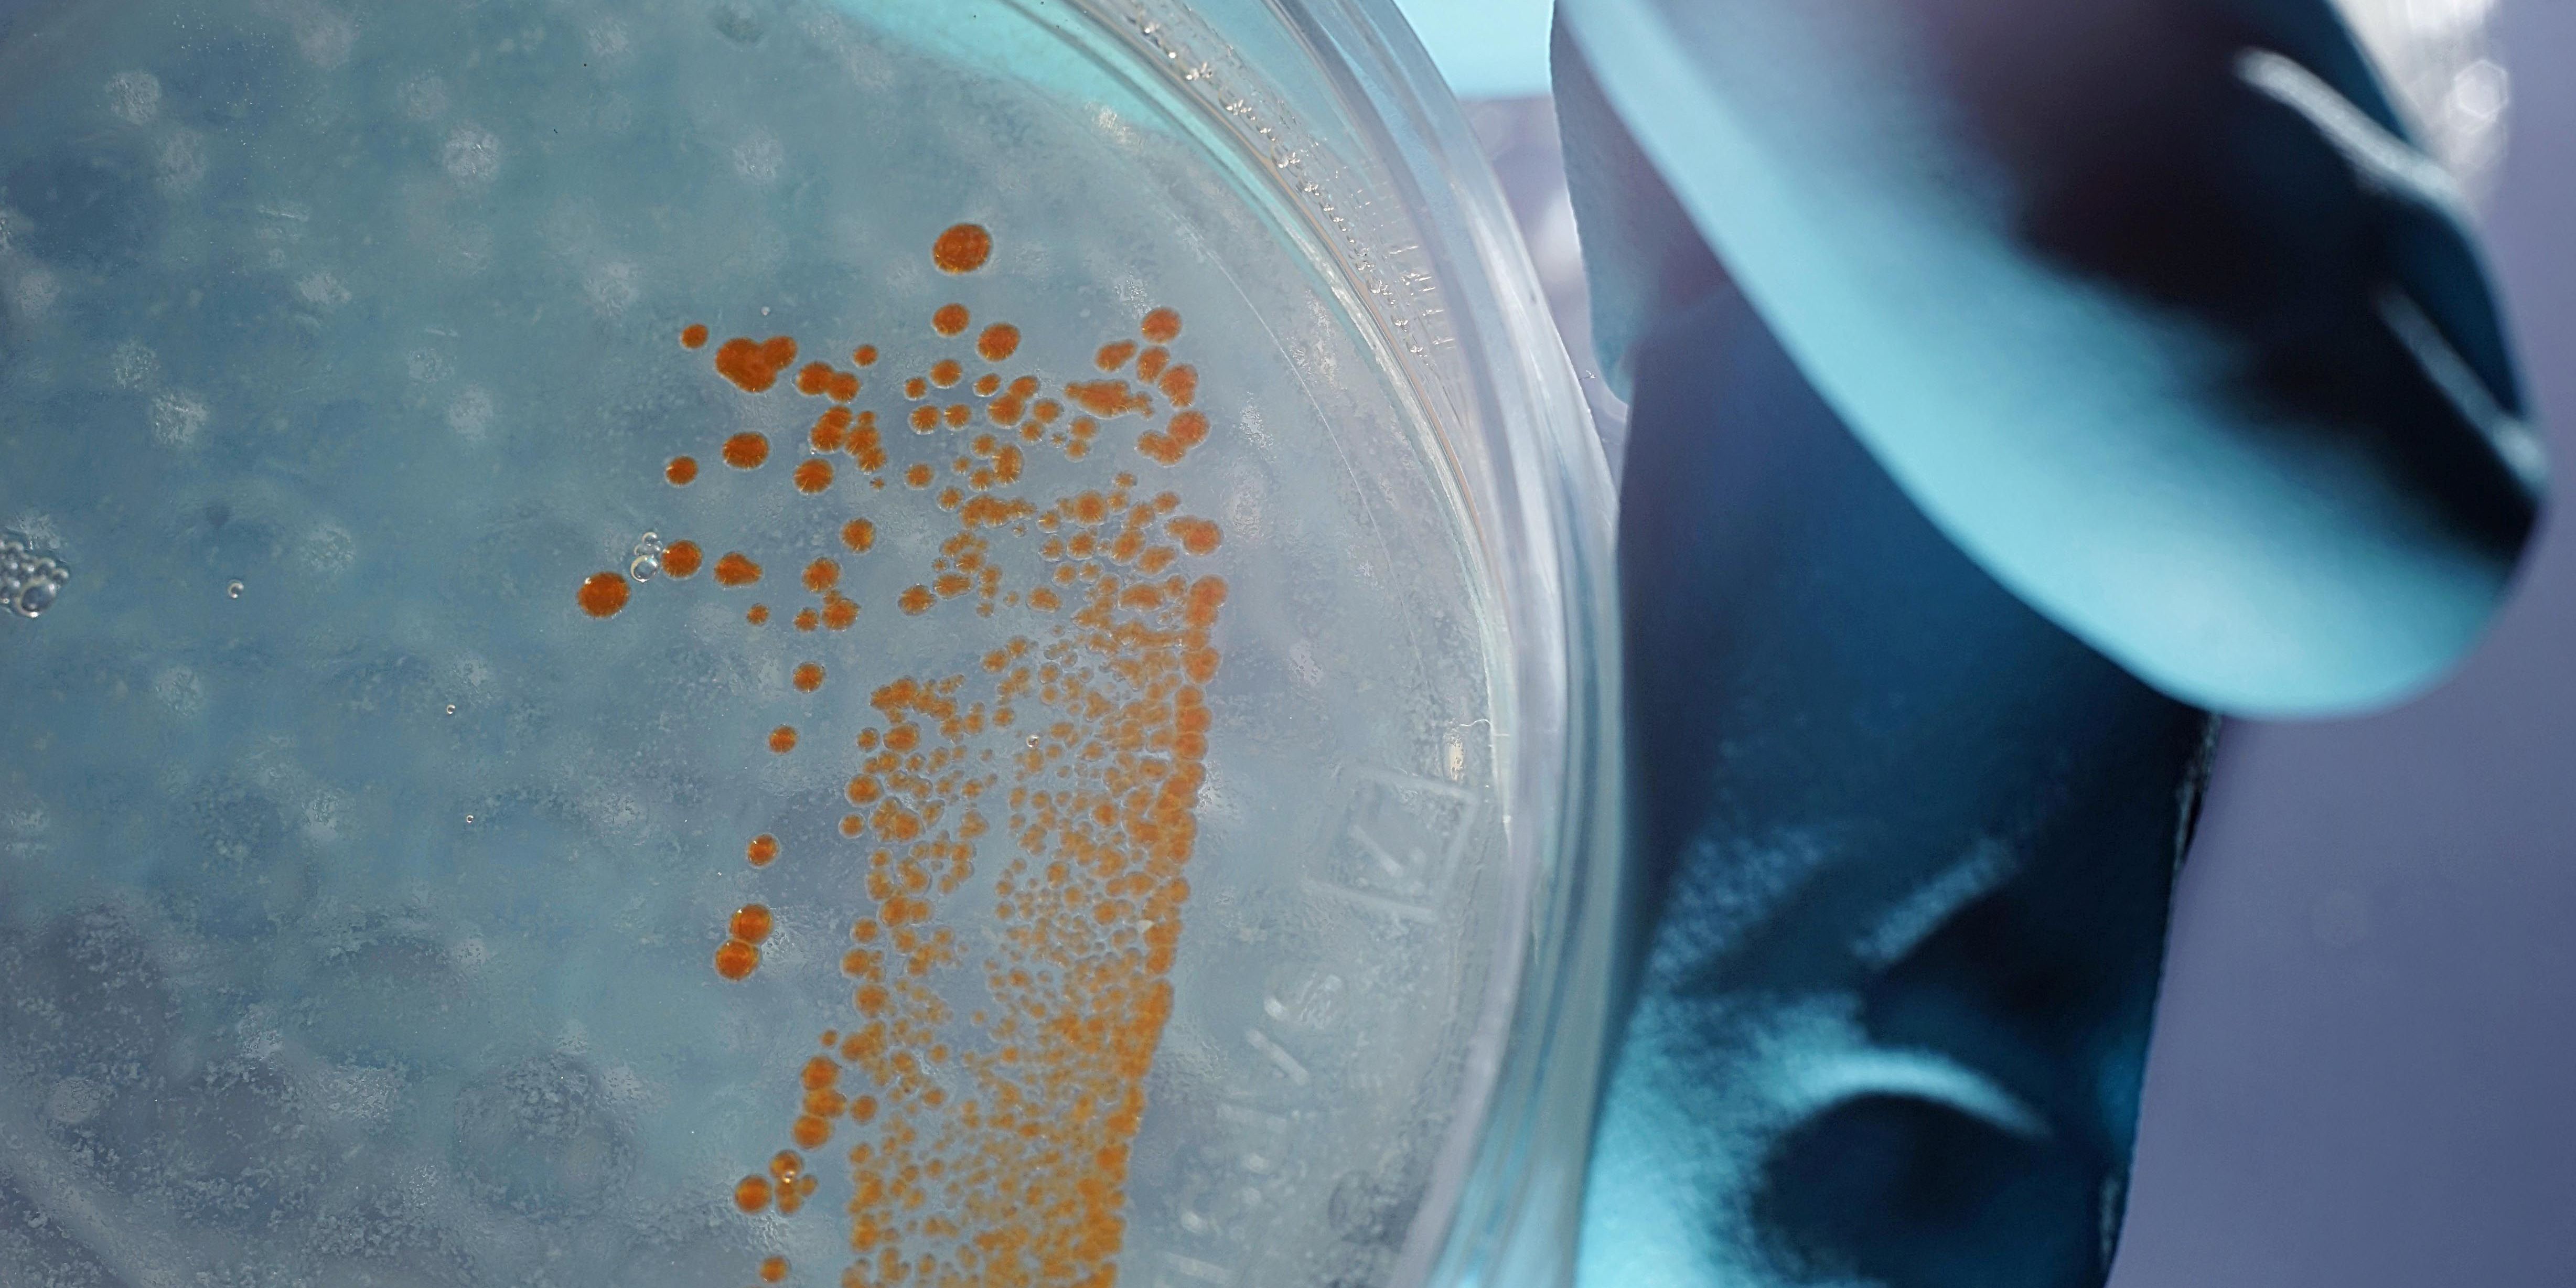
Neue Förderphase für chemisches Beziehungsgeflecht

Neue Förderphase für chemisches Beziehungsgeflecht
Der Sonderforschungsbereich ChemBioSys der Universität Jena ist in eine neue Förderphase gestartet. Die Deutsche Forschungsgemeinschaft unterstützt den Verbund in den nächsten vier Jahren mit weiteren rund 9,5 Millionen Euro. Die Wissenschaftler untersuchen in 21 Einzelprojekten die komplexen Kommunikationswege und Wechselbeziehungen verschiedener Organismen und ihrer Umwelt. Im Fokus stehen dabei Naturstoffe, die hier als Vermittler dienen – praktisch als chemische Sprache der Natur. Mit diesem Forschungsansatz bildet der Sonderforschungsbereich eine zentrale Säule des Forschungsclusters Balance of the Microverse, mit dem sich die Uni Jena im Rahmen der Exzellenzstrategie des Bundes und der Länder bewirbt. Weitere Informationen gibt es unter www.chembiosys.de. cd Foto: Jan-Peter Kasper/FSU






















Klarer Himmel